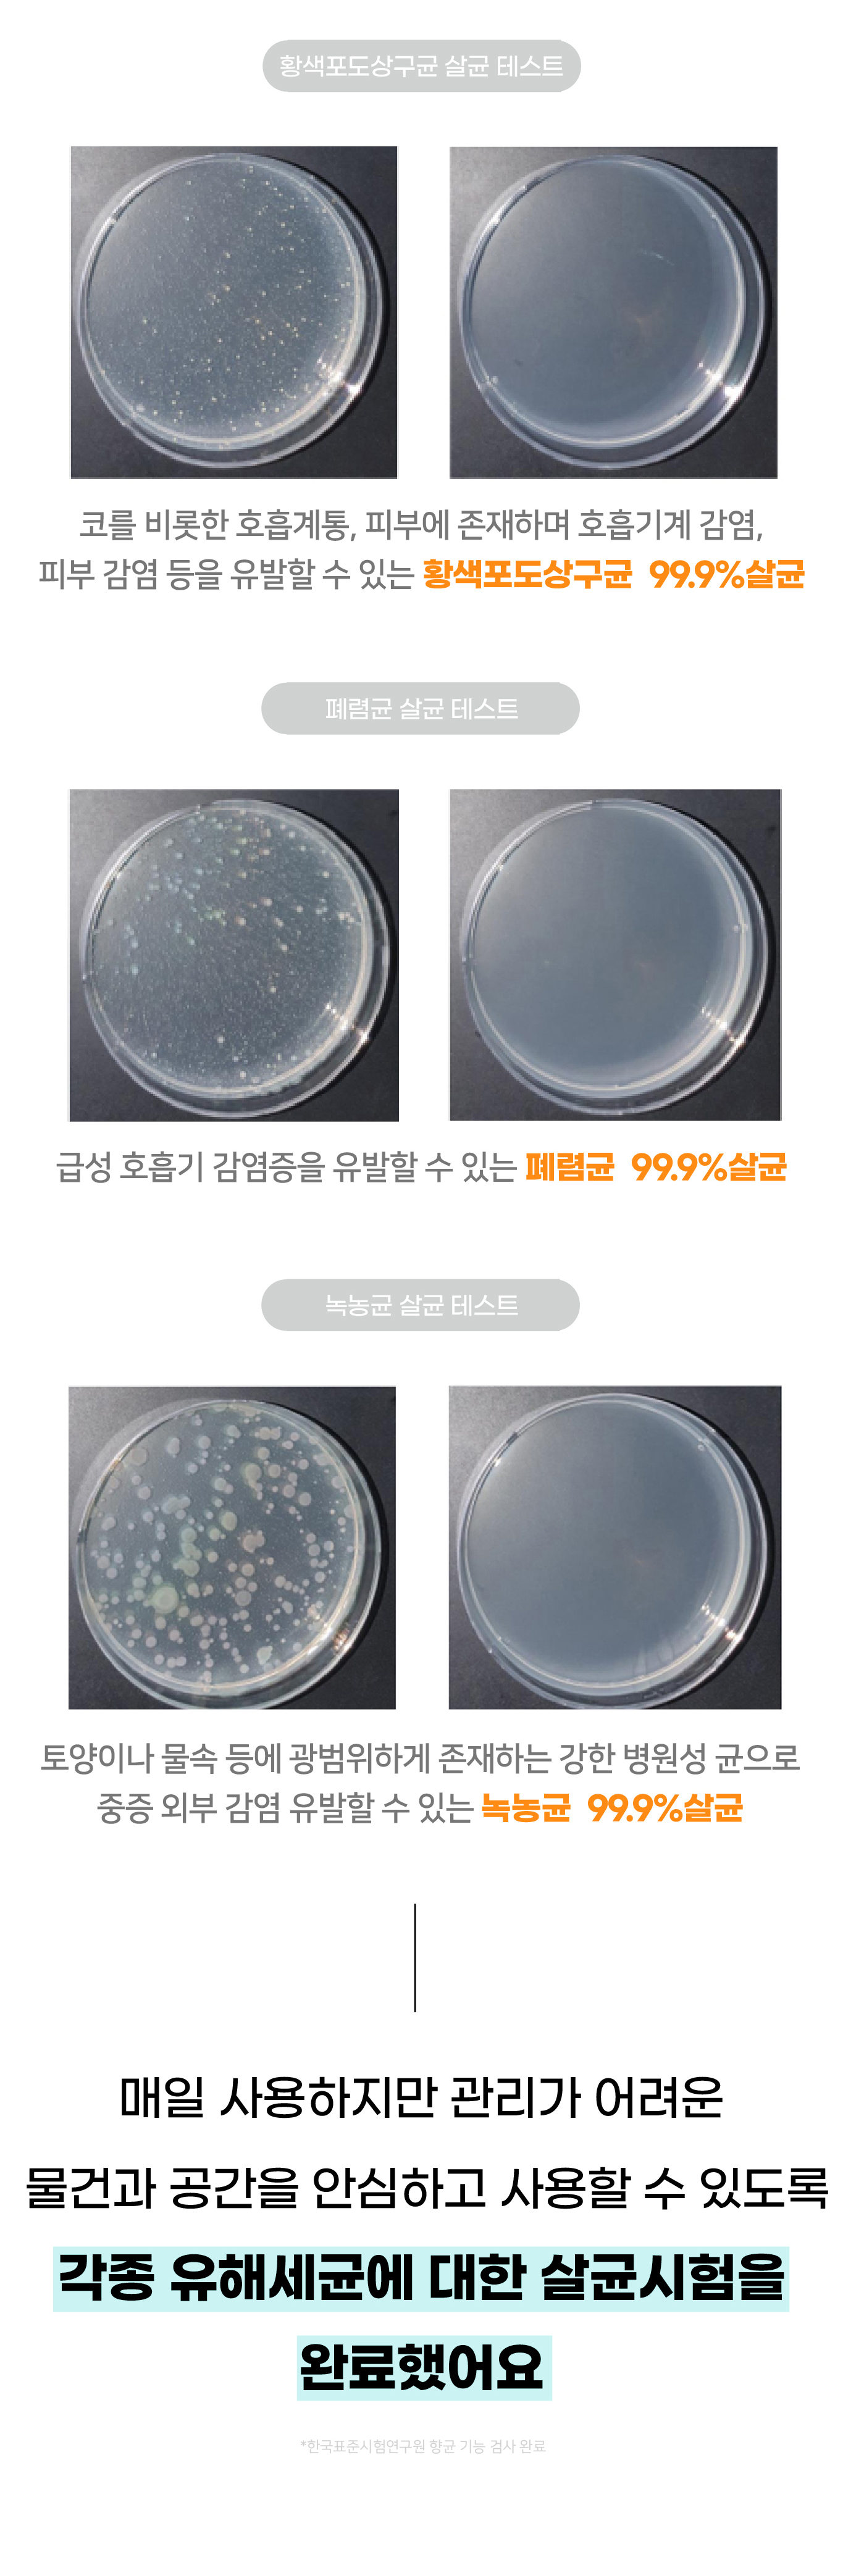
세균.jpg

암모니아 - 무색의 기체로 자극적인 지독한 냄새가 특징 (화장실 냄새, 땀 냄새, 쉰 냄새 등)
암모니아 - 무색의 기체로 자극적인 지독한 냄새가 특징 (화장실 냄새, 땀 냄새, 쉰 냄새 등)
포름알데하이드- 자극성 냄새가 나는 휘발성 화합물로 1군 발암요인 중 하나 (새집증후군)
트리메틸아민 - 썩는 듯한 고약한 냄새를 풍기는 것이 특징 (생선 냄새, 암내, 몸 냄새 등)

성공금 사용 계획
먼슬리121는 펀딩 성공금은 신제품 개발에 사용됩니다.
반환 정책 및 교환A/S 정책
• 서포터 부주의로 인한 손상 또는 박스 개봉시 교환/ 반환/반품이 불가능합니다.
• 교환 및 성공금 반환 기간인 7일이 경과된 제품인 경우교환이 불가능합니다.
• 교환 요청 시 와디즈 메시지 또는 C/S센터070.7178.8899 로 문의 부탁드립니다.
• 이 외의 모든 사항은 와디즈 운영 정책을 따릅니다.
배송 방법
• CJ대한통운 배송을 통해 순차적 발송
• 도서/산간지방의 경우 배송비 3,000원 을 추가로 펀딩해주세요.
• 배송 관련 문의 카카오톡 플러스 친구 : 먼슬리121
*문의는 평일 10:00 ~ 17:00 에 가능합니다
 먼슬리121
먼슬리121
